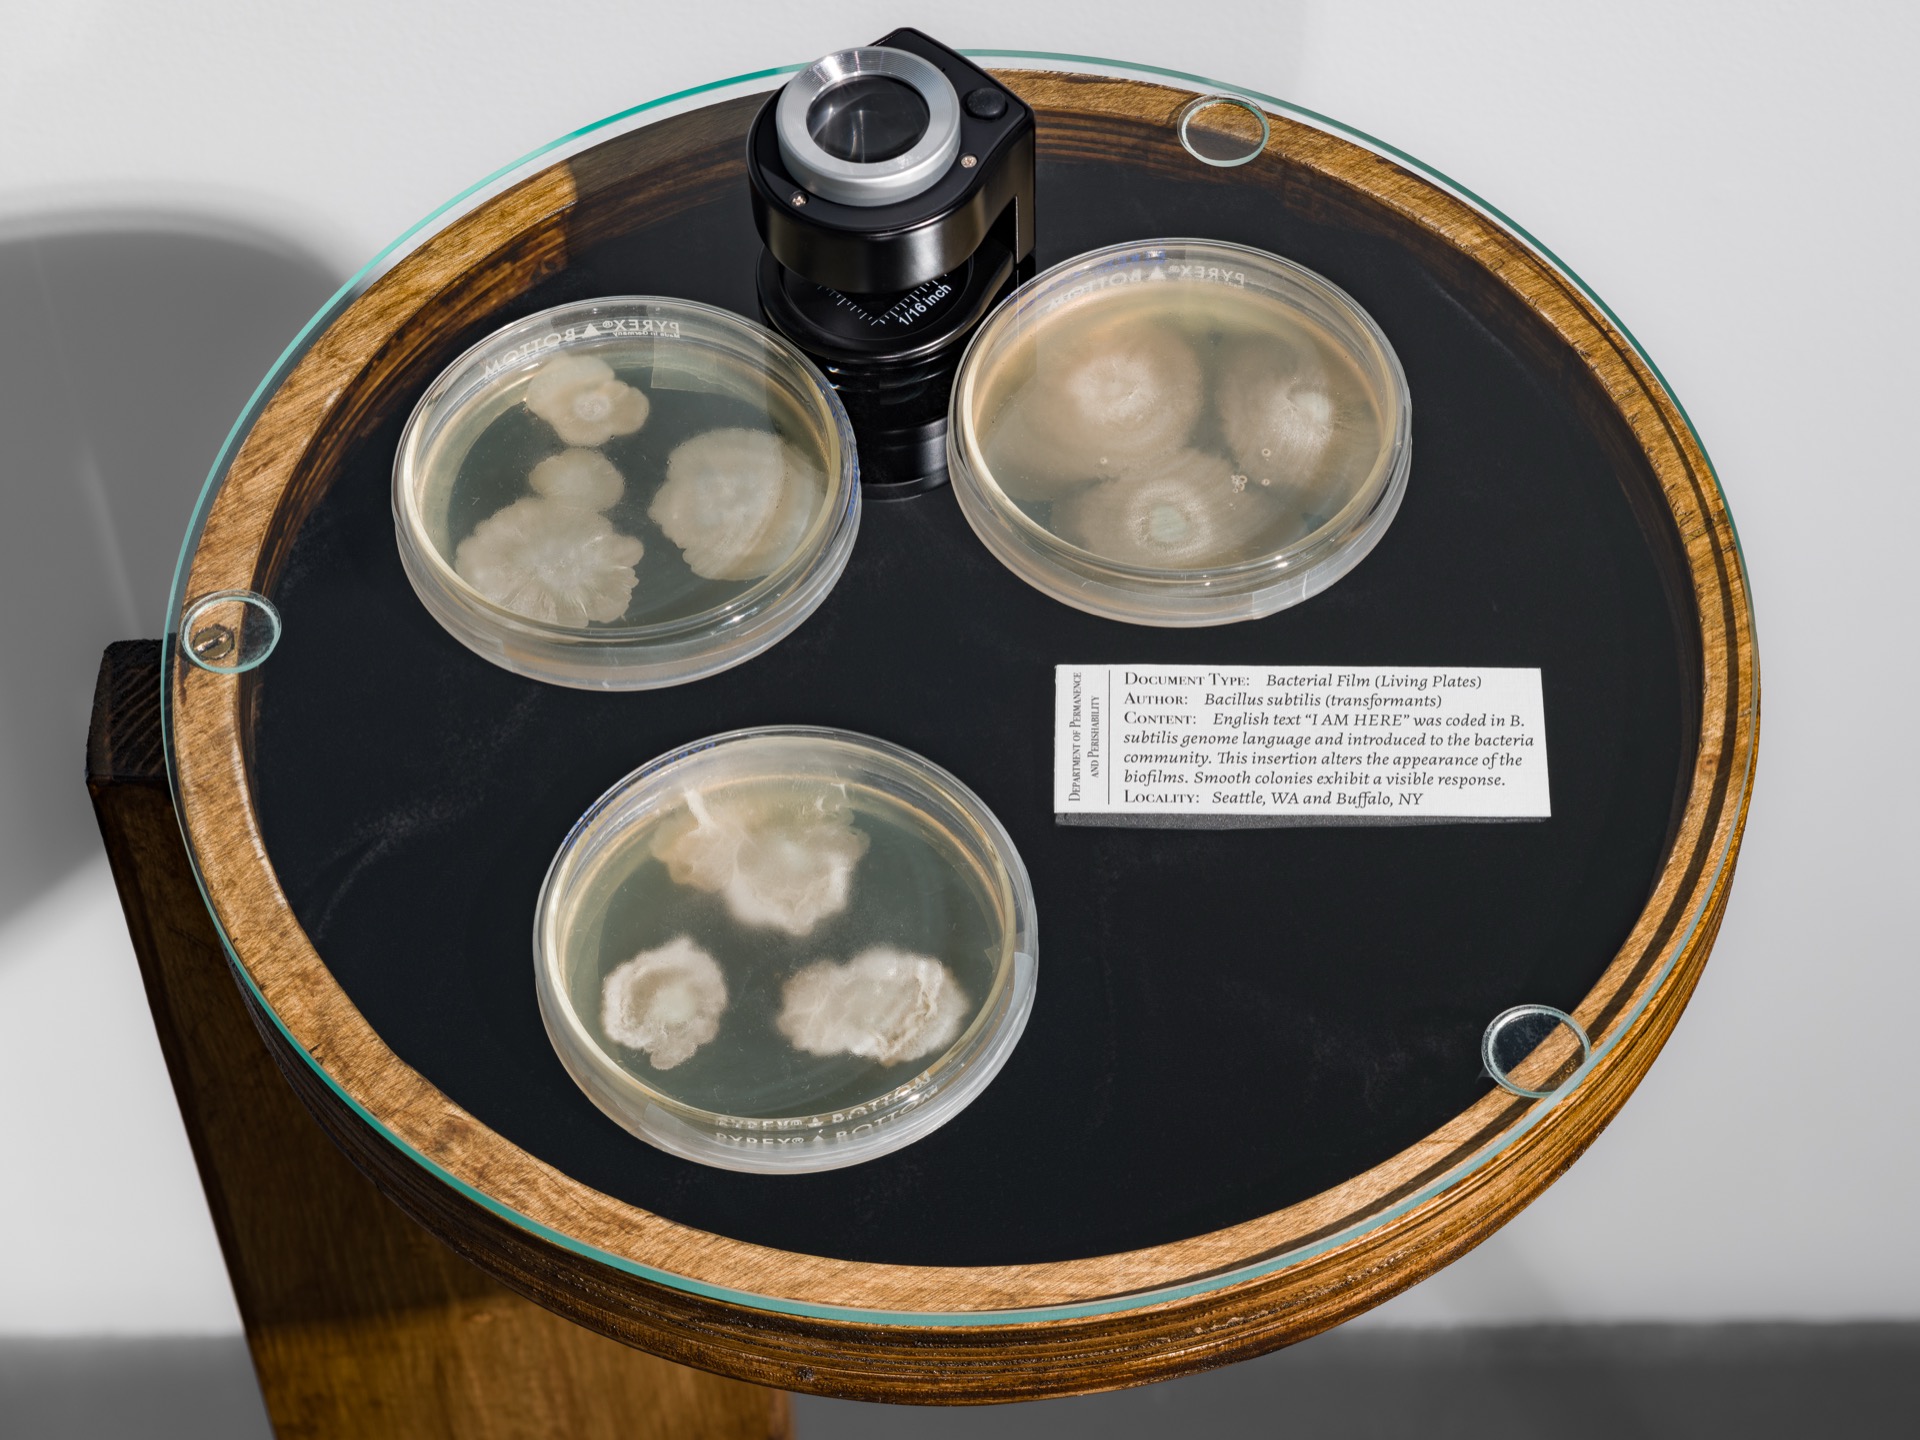

Commit to Memory, Know It Will Perish
Commit to Memory, Know it Will Perish examines the fragility and transformation of memory within biological and technological systems. Developed during a residency at the Coalesce Center for Biological Arts and grounded in research at at DXARTS and the Molecular Information Systems Lab at the University of Washington, Althea Rao considers how human information can be preserved when inserted as DNA molecules into other living organisms—as long as the host remains alive.
Exploring artist Cecilia Vicuña’s claim that “writing creates forgetfulness, weaving creates memory,” Rao investigates the tensions between encoded information and embodied sensation, between human data and microbial behavior, asking, how is knowledge held or lost? The exhibition unfolds through living, decomposing, and metabolizing installations that resist stable meaning. In them, data is not preserved for reading, but instead made available for digestion, metabolization, and decay in bacterial film and cellulose sheets grown from yeast. These microbial substrates evoke the “wordless book from the sky (無字天書),” a Chinese term for pages that transmit meaning without written language.
Together these works form a living archive. Wax strips from a local salon record human presence through its transient remnants; a recurring gesture involves encoding the phrase “I am here” into synthetic DNA molecules, then introducing those molecules into developing bacterial communities. These gestures, seemingly banal, suggest a different kind of legacy, one offered to microbial communities and inaccessible to humans.
Instead of seeking permanence through data collection and digital storage, Rao proposes a more imprinted and internalized practice: to commit memory to the body, recognize its perishability, and imagine its shared presence with nonhuman agents.
This exhibition was supported by a 4Culture Arts Project Grant.